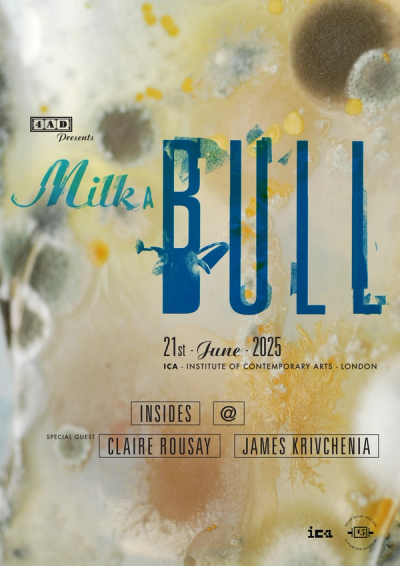

This Summer Solstice (21 June), 4AD will present Milk A Bull, an evening of music at London’s Institute of Contemporary Arts (ICA). As the longest day turns into night, members of 4AD’s family and friends will take to the stage, with performances from Jenny Hval, new signing @, Insides (who originally performed at 13 Year Itch), Claire Rousay and Big Thief’s James Krivchenia who will close out the evening. Plus sets from NTS DJs Alexander Nut and Gabi.
4AD presents Milk A Bull4AD presents Milk A Bull
ft. @, Insides, Claire Rousay, James Krivchenia, Jenny Hval
ICA
- Saturday 21 June